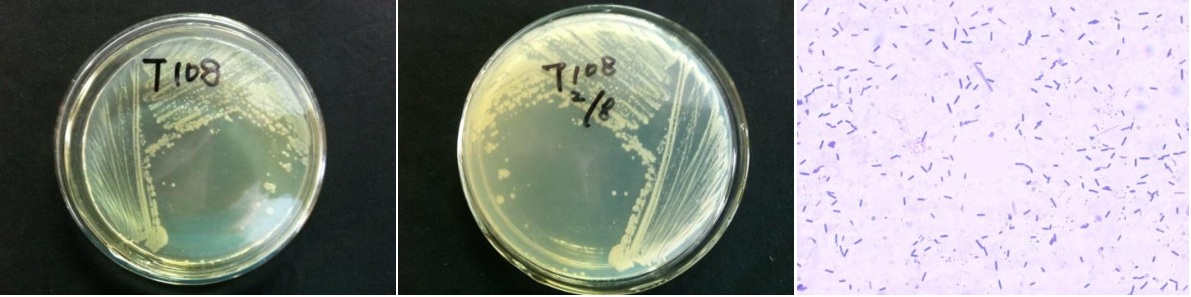

Loading...
| StrainNO | B392 |
| Classification | Aneurinibacillus |
| 16s rDNA sequence | TCGGCGGCTGGCTCCTTGCGGTTACCTCACCGACTTCGGGTGTTGCAAACTCTCGTGGTGTGACGGGCGGTGTGTACAAGACCCG GGAACGTATTCACCGCGGCATGCTGATCCGCGATTACTAGCGATTCCGGCTTCATGCAGGCGAGTTGCAGCCTGCAATCCGAACT GAGAATGGTTTTAAGGGATTCGCGCACTCTCGCGAGTTGGCTGCCCGTTGTTCCATCCATTGTAGCACGTGTGTAGCCCAGGACA TAAGGGGCATGATGATTTGACGTCATCCCCACCTTCCTCCGTCTTGTCGACGGCAGTCTCCCTAGAGTGCCCAACTAAATGCTGG CAACTAAGGACAAGGGTTGCGCTCGTTGCGGGACTTAACCCAACATCTCACGACACGAGCTGACGACAACCATGCACCACCTGTC ACCGCTGCTCCGAAGAGAGCTCCTATCTCTAGGAGGGTCAGCGGGATGTCAAGCCCTGGTAAGGTTCTTCGCGTTGCTTCGAATT AAACCACATGCTCCACCGCTTGTGCGGGTCCCCGTCAATTCCTTTGAGTTTCAGCCTTGCGGCCGTACTCCCCAGGCGGAGTGCT TATTGCGTTAGCTGCGGCACTGAGGATTGGAGTCCCCAACACCTAGCACTCAACGTTTACGGCGTGGACTACCAGGGTATCTAAT CCTGTTCGCTCCCCACGCTTTCGCGCCTCAGCGTCAGTTACAGGCCAGAGAGCCGCCTTCGCCACGGGTGTTCCTCCACATCTCT ACGCATTTCACCGCTACACGTGGAATTCCGCTCTCCTCTCCTGCACTCAAGCTTCCCAGTTTCAAGTGGCCCTCCACGGTTGAGC CGTGGGCTTTCACACCTGACTTAAGAAGCCGCCTGCGCGCGCTTTACGCCCAATAATTCCGGACAACGCTTGCCCCCTACGTATT ACCGCGGCTGCTGGCACGTAGTTAGCCGGGGCTTTCTCGTTAGGTACCGTCAGACCGGGAGGTCATCCCGGCGGTTCTTCCCTAA CAACAGAACTTTACGATCCGAAAACCTTCATCGTTCACGCGGCGTTGCTCCGTCAGACTTTCGTCCATTGCGGAAGATTCCCTAC TGCTGCCTCCCGTAGGAGTCTGGGCCGTGTCTCAGTCCCAGTGTGGCCGATCACCCTCTCAGGTCGGCTACGCATCGTCGCCTTG GTAGGCCGTTACCCCACCAACTAGCTAATGCGCCGCAGGCCCATCTGTACGTGACCAAAGGTCTTTCCCTTTCAGACCATGCGGT CTGAAAAAAGTATCCGGTATTAGCTCCGGTTTCCCGGAGTTATCCCAGTCGTACAGGCAGGTTGCCTACGTGTTACTCACCCGTC CGCCGCTAACCGCCGAAGAGCAAGCTCTTCATTGGTCCGCTCGACTTGCATGTATAGC |
| Strain Morphology Photos | |
| Morphological Description | Colony round;light yellow;steamed bun shaped;edge neatly;bright;sticky;Waxed;Rod;having spore;Bacteriophage telogen |